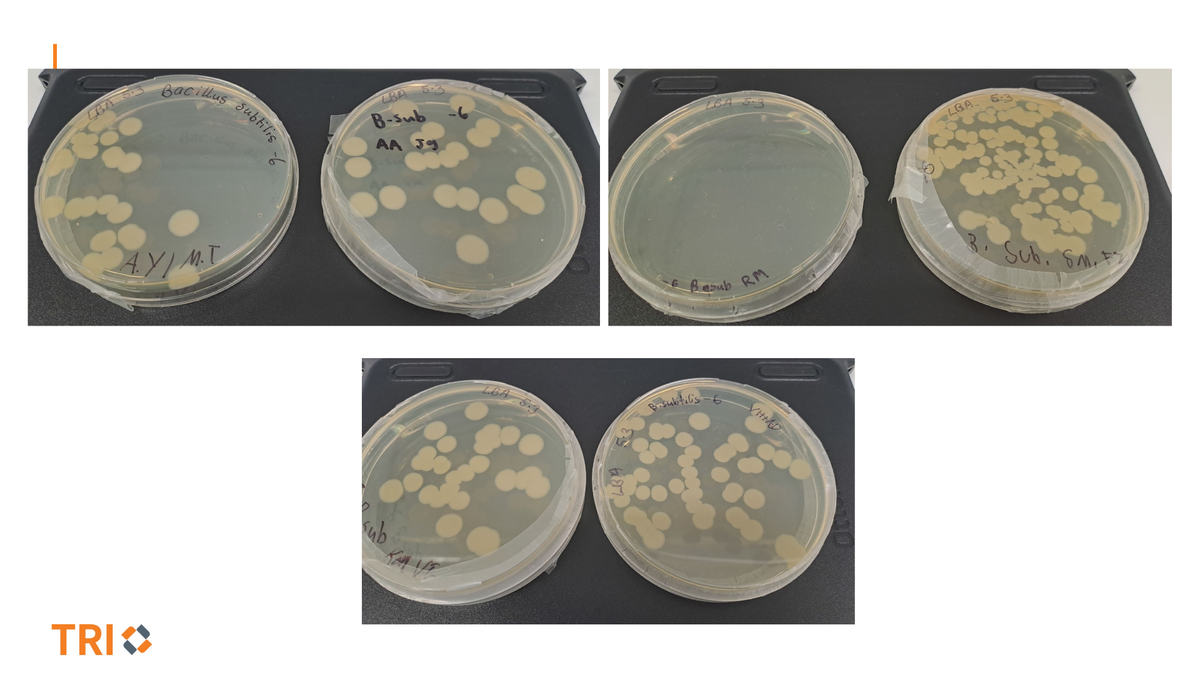
Gallery Image
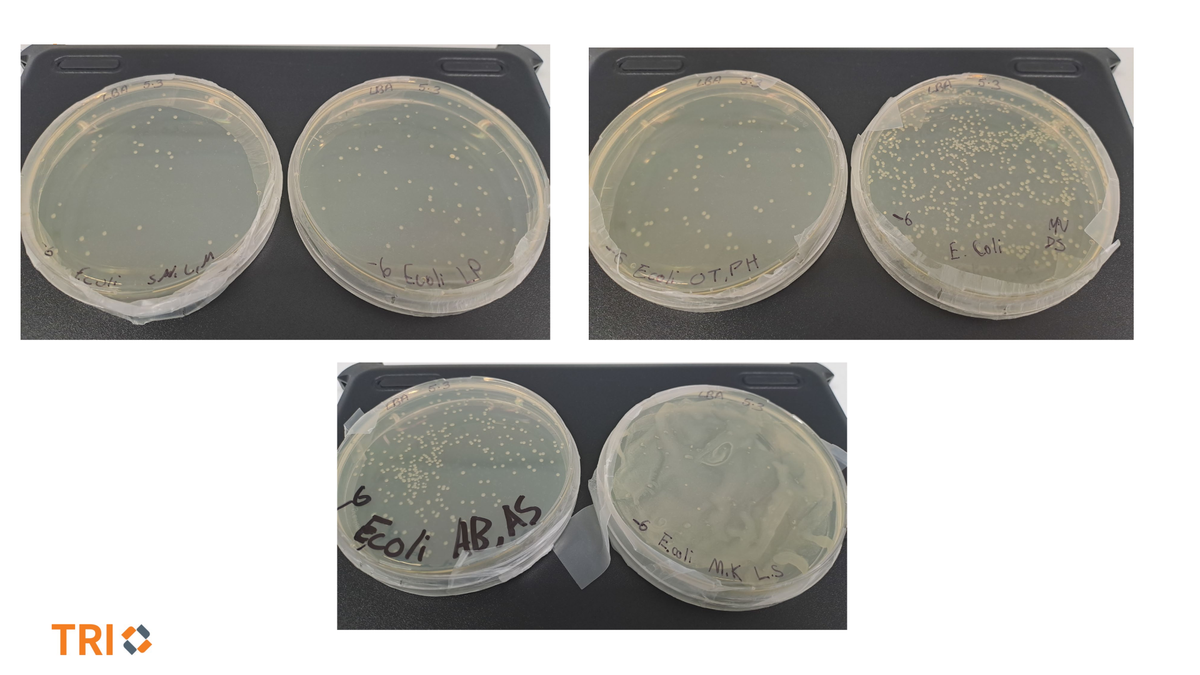
Gallery Image

Snapshots from the week

SPARQ-ed Laboratory at the Translational Research Institute
Last Friday, our Year 7 students attended an exciting excursion to the SPARQ-ed Laboratory at the Translational Research Institute, where they took part in a Microbiology Detective workshop.
Students gained hands-on experience using real laboratory equipment, including micropipettes, while exploring key microbiology techniques such as serial dilutions, spectrophotometry, colony counting, and microscopy. They investigated important scientific questions around how bacterial cells are counted and identified, working with safe microorganisms including E. coli and Bacillus subtilis.
In the second part of the workshop, students applied their skills as “microbiology detectives,” using biochemical tests to distinguish between different bacterial species.
The experience was highly engaging, with students particularly enjoying the opportunity to work like real scientists in a professional lab setting. Overall, the excursion sparked curiosity and deepened their understanding of microbiology.
QFSL v Lowood
Strong performance from the boys in the QFSL clash against Lowood
A great team effort from start to finish, with plenty of quality on display. Big thanks to the students who came down and brought the energy on the sidelines — your support makes a difference
15 Minutes of Fame 🎤
‘15 Minutes of Fame’ is a fantastic opportunity for Balmoral students to showcase their talents and build confidence performing in front of a supportive audience.
The event provides a safe and encouraging environment for students to step into the spotlight, while also giving others the chance to enjoy live entertainment during their lunch break.